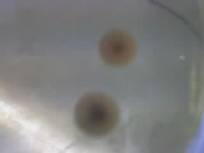

RELAZIONE LABORATORIO DI BIOLOGIA
LA
CARICA BATTERICA TOTALE
Con questa
esperienza analizziamo un campione d'acqua per determinare la sua C.B.T. e stabilire quindi se si tratta
di acqua potabile o no.
Per C.B.T. o
carica batterica totale di un campione si intende il numero di batteri
contenuti in un ml di esso (n° di batteri/ml).
Iniziamo con
il preparare un terreno di coltura costituito da sostanze capaci di mantenere
la vitalità e di permettere la riproduzione dei batteri fuori dal loro ambiente
naturale di vita. I terreni colturali si dividono in terreni liquidi e terreni
solidi che a loro volta possono essere terreni ricchi, terreni di arricchimento
e selettivi, terreni di identificazione e terreni coagulati.
Per la
nostra analisi utilizziamo un terreno
solido contenente agar che si ottiene aggiungendo l'agar al terreno
liquido. L'agar è una sostanza gelatinosa costituita da polisaccaridi che si
estrae da alcuni tipi di alghe marine e che ha solo una funzione solidificante
del brodo, in quanto il suo apporto nutritivo è nullo.
Le
temperature caratteristiche dell'agar sono quella di fusione a circa 80° e
quella di solidificazione che è intorno ai 42/43°.
Per
preparare questo terreno seguiamo delle fasi ben precise. Prima fase è quella
della pesata degli ingredienti che occorrono per preparare il terreno;
per calcolare la giusta quantità di grammi da prelevare utilizziamo una
proporzione, leggendo anche le indicazioni sulla bottiglia contenente il
terreno: 1000ml : gr sulla confezione = ml da preparare : x gr da pesare.
Siccome dobbiamo preparare 180ml di terreno e i gr/l sulla confezione sono 20,5
noi dobbiamo pesare 3,7
grammi di terreno. Dopo facciamo la dissoluzione
degli ingredienti che avviene in un contenitore di vetro e sempre con acqua
distillata. La facciamo inoltre su un becco bunsen perché il calore favorisce
lo scioglimento completo di alcuni composti del terreno; occorre però limitare
il riscaldamento, per evitare che un'ebollizione prolungata modifichi le
caratteristiche del terreno. La fase successiva è quella dell'aggiustamento
del ph. Questa è una fase molto importante perché alcuni batteri non si
riproducono in condizioni eccessivamente acide o basiche. Effettuiamo il
controllo con una cartina universale che poi paragoniamo con una scala colorata
corrispondente ai diversi valori del ph: se questo è maggiore di 7 la soluzione
è basica e dobbiamo aggiungere acido cloridrico al 5%, se invece è inferiore a
7 aggiungiamo idrato di sodio in quanto la soluzione è acida. Siccome il valore
del ph del nostro terreno è 7, passiamo alla distribuzione in recipienti di
vetro. Durante questa fase distribuiamo, appunto, 15 ml di terreno in 10
diverse provette utilizzando una pipetta sterile e poi passiamo alla sterilizzazione
del terreno e al controllo della sua sterilità che vengano però
eseguite dal professore. Per la sterilizzazione le provette vengono messe
nell'autoclave a 120° per 20/30 minuti dopo di che, per assicurarci che il
terreno sia sterile vengono incubate nel termostato a 37° per circa 48 ore.
Finito il periodo di incubazione occorre passare alla conservazione del
terreno; anche questa è una fase importante in quanto il terreno deve
essere conservato in frigo alla temperatura di 4°C altrimenti l'evaporazione
dell'acqua potrebbe causare la diminuzione della quantità d'acqua
indispensabile alla vita dei batteri. Mentre il terreno viene conservato in
frigo, prepariamo anche i campioni che poi semineremo nel terreno. Dobbiamo
infatti fare diverse diluizioni del campione per evitare che ci sia un
eccessivo sviluppo delle colonie dei batteri che poi non riusciamo a contare.
Facciamo quindi 4 diluizioni diverse in modo che la quantità di campione
presente nel terreno sia sempre meno. La diluizione
avviene mescolando il campione con acqua distillata secondo delle proporzioni.
Prendiamo allora 8 provette e le dividiamo in due gruppi di 4: la diluizione
sarà la stessa per i due gruppi ma cambierà poi l'incubazione, una volta
avvenuta la semina. Le numeriamo da 1
a 4; nelle provette 1 mettiamo metà quantità d'acqua
distillata(5ml) e metà di campione(5 ml): in queste provette la diluizione sarà
di 1:2. Nelle provette 2 inseriamo
1ml di campione e 9 ml di acqua distillata: in questo caso avremo una
diluizione di 1:10 che significa che
in 1 ml di soluzione avremo 0,1 ml di campione. Nelle provette 3 mettiamo 1ml
di soluzione 1:10 e 9ml di acqua distillata: qui la diluizione sarà di 1:100 poiché, sul volume totale di 10ml,
avremo solo 0,1ml di campione derivanti dalla diluizione precedente. Facciamo
in questo modo anche per le provette 4 dove inseriamo 9ml di acqua e 1ml di
soluzione 1:100, dove abbiamo solo 0,01ml di campione, ottenendo una diluizione
1:1000. Ricordiamoci che tutti
questi trasferimenti devono essere fatti con pipette sterili. Ora prendiamo 10 piastre Petri e le dividiamo in due
gruppi da 5; prendiamo i terreni dal frigorifero e le provette con il campione
diluito. A questo punto possiamo iniziare la semina per inclusione: si parla di semina quando inoculiamo
direttamente il campione contenente i batteri nel terreno e, parliamo di semina
per inclusione quando, con la semina, il campione liquido viene incluso,
mescolandolo uniformemente, in un terreno semisolido, o agar. Usando pipette
sterili diverse per ogni "diluizione" mettiamo in tutte le piastre 1ml di
campione: nella prima inseriremo 1ml di campione puro. nella seconda 1ml di
soluzione 1:2, nella terza 1ml di soluzione 1:10, nella quarta di soluzione
1:100 e nell'ultima di soluzione 1:1000. Nell'eseguire questa operazione
dobbiamo essere rapidi nell'aprire la piastra e inoculare il campione per non
rischiare contaminazioni esterne. A questo punto inseriamo nelle piastre anche
i 15ml di terreno e mescoliamo uniformemente con piccoli movimenti rotatori della
piastra. Una volta che il terreno si sarà solidificato dividiamo le piastre in
due gruppi e le incubiamo, ma con temperatura e tempi diversi. Le prime le
incubiamo a 22°C
per 72 ore mentre le altre le incubiamo a 37°C per 48 ore. In questo modo possiamo
calcolare la carica batterica totale nelle piastre dovuta a batteri diversi: a
22°, infatti, si svilupperanno batteri
di origine tellurica presenti normalmente nel terreno, mentre a 37°quelli
di origine animale e quindi batteri
fecali. Alla fine dell'incubazione passiamo alla lettura dei risultati.
Partiamo con il controllare che tutto sia stato svolto correttamente e quindi
per prima cosa osserviamo il modo in cui le colonie di batteri si sono
sviluppate: quelle incluse nel terreno, piccole e di forma ellittica saranno
colonie di batteri presenti nel campione e perciò da considerare, quelle
grandi, colorate e sviluppate sulla superficie, saranno dovute invece, a
batteri non presenti nel campione ma arrivati nella piastra con contaminazioni
esterne, e non sono da considerare. Inoltre se il lavoro è stato eseguito bene
il numero delle colonie deve diminuire all'aumentare della diluizione. Una
volta controllato tutto questo iniziamo la conta delle colonie e il calcolo
della C.B.T.. Scegliamo le piastre idonee al conteggio che generalmente sono
quelle con un numero di colonie compreso tra 30 e 300 e quelle in cui lo
sviluppo è avvenuto in modo omogeneo. Partiamo dalla prima piastra e iniziamo a
contare: se questa fosse troppo popolata possiamo dividerla in parti uguali,
contare le colonie presenti in una parte e moltiplicare per il numero delle
parti, visto che lo sviluppo dovrebbe essere omogeneo. Per quanto riguarda le
piastre successive, dopo aver contato moltiplico per il fattore di diluizione,
in questo modo posso confrontare subito i risultati perché, moltiplicando, mi
riferisco sempre al millilitro di campione puro della prima piastra. Alla fine
del conteggio di tutte le piastre facciamo la media aritmetica fra i risultati
ottenuti; ovviamente nella media non includiamo le piastre che sono state
considerate non idonee al conteggio. Stabilita poi la carica batterica totale
del campione per entrambi i tipi di batteri lo confrontiamo con i limiti
stabiliti dalla legge: per i batteri tellurici il valore massimo è 100
colonie/ml mentre per quelli fecali è 10 colonie/ml. Notiamo che il rapporto
tra i due tipi di batteri è di 1:10. Il nostro campione è acqua potabile poiché
la C.B.T. è zero.
Nelle piastre infatti non è presente nessuna colonia di batteri ma solo alcune
muffe che però provengono da contaminazioni esterne e non sono quindi da
considerare. Una delle piastre a °C
non si è nemmeno solidificata e quindi non è stata inclusa nella media
aritmetica mentre nella prima piastra a °C si è formata una piccola colonia di batteri che però non è ancora
accettabile poiché è l'unica.
muffe nella piastra muffe nella
prima piastra e unica colonia di batteri sviluppatasi